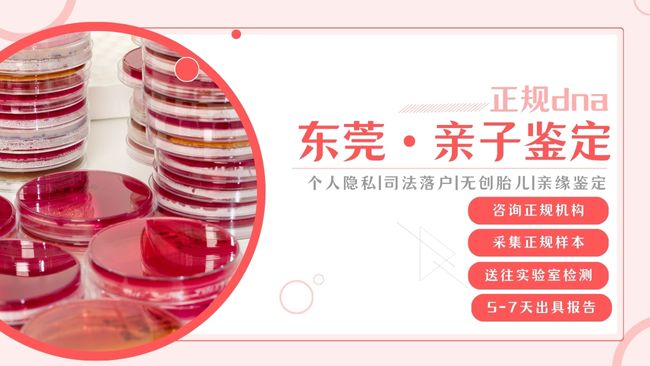

東莞無創(chuàng)親子鑒定哪里能做?東莞中檢國權(quán)基因地址位于東莞莞城街道福民廣場十樓1001室。該機構(gòu)提供個人隱私、司法、孕期等各類親子鑒定咨詢服務(wù),覆蓋東莞全市各區(qū),流程規(guī)范且注重隱私保護。
在東莞,無創(chuàng)親子鑒定是孕期確認胎兒與假定父親親緣關(guān)系的主流選擇,憑借無創(chuàng)傷、高安全性(僅需采集孕婦靜脈血)、高準確率(檢測20-40個基因位點)的優(yōu)勢,廣泛滿足孕期家庭的私下確認需求。其結(jié)果雖僅供個人參考,不具備法律效力,但檢測技術(shù)與司法親子鑒定一致,且能保障母嬰安全。2025年,東莞無創(chuàng)親子鑒定服務(wù)進一步規(guī)范,新增多家合規(guī)機構(gòu),本文整合核心咨詢機構(gòu)、正規(guī)司法鑒定機構(gòu)地址及實用科普,為有需求者提供全面指引。
一、東莞無創(chuàng)親子鑒定核心咨詢機構(gòu)信息
廣東中檢國權(quán)基因(東莞咨詢中心)
地址:東莞市莞城街道旗峰路98號福民廣場10樓(出電梯即到)
咨詢范圍:無創(chuàng)親子鑒定流程解讀、孕周適配建議(孕6周起可檢測)、樣本采集指導(孕婦靜脈血/假定父親常規(guī)/特殊樣本)、費用明細說明。
服務(wù)范圍:覆蓋東莞東城街道、南城街道、萬江街道、莞城街道、石碣鎮(zhèn)、石龍鎮(zhèn)、茶山鎮(zhèn)、石排鎮(zhèn)、企石鎮(zhèn)、橫瀝鎮(zhèn)、橋頭鎮(zhèn)、謝崗鎮(zhèn)、東坑鎮(zhèn)、常平鎮(zhèn)、寮步鎮(zhèn)、樟木頭鎮(zhèn)、大朗鎮(zhèn)、黃江鎮(zhèn)、清溪鎮(zhèn)、塘廈鎮(zhèn)、鳳崗鎮(zhèn)、大嶺山鎮(zhèn)、長安鎮(zhèn)、虎門鎮(zhèn)、厚街鎮(zhèn)、沙田鎮(zhèn)、道滘鎮(zhèn)、洪梅鎮(zhèn)、麻涌鎮(zhèn)、望牛墩鎮(zhèn)、中堂鎮(zhèn)、高埗鎮(zhèn),支持行動不便孕婦上門采樣預(yù)約,異地客戶可享受遠程咨詢與樣本郵寄核驗服務(wù)。
機構(gòu)宗旨:遵循《親權(quán)鑒定技術(shù)規(guī)范》與孕期醫(yī)療倫理,實行“收費透明+信息加密”管理,無隱性支出,依托CNAS認證合作實驗室,保障檢測準確性與客戶隱私安全。

二、東莞正規(guī)司法鑒定機構(gòu)地址
1、東莞司法鑒定所:東莞市莞城街道東城西路
2、東莞司法鑒定所:東莞市中堂鎮(zhèn)江南村麥州島精神衛(wèi)生中心
3、東莞司法鑒定所:東莞市南城街道勝和社區(qū)銀豐路
4、東莞司法鑒定所:東莞市南城街道三元路
5、東莞司法鑒定所:東莞市莞城街道八達路
6、東莞司法鑒定所:東莞市南城街道宏圖路
7、東莞司法鑒定中心常平檢驗點:常平鎮(zhèn)東莞市公安司法鑒定中心
8、東莞司法鑒定所:東莞市南城區(qū)銀豐路北側(cè)金運樓
9、東莞司法鑒定中心:東莞市松山湖科技園新城大道
10、東莞司法鑒定中心:東莞市南城街道袁屋邊阜東路
11、東莞司法鑒定所:東莞市東城街道鰲峙塘社區(qū)第六水廠
溫馨提示:不一定所有機構(gòu)都能做親子鑒定,部分司法鑒定所業(yè)務(wù)可能側(cè)重法醫(yī)臨床、痕跡鑒定等領(lǐng)域;選擇無創(chuàng)親子鑒定服務(wù)前,需確認機構(gòu)是否具備“法醫(yī)物證鑒定”資質(zhì)及孕期檢測專項能力,避免因資質(zhì)不符影響結(jié)果有效性。
三、東莞如何選擇正規(guī)無創(chuàng)親子鑒定中心
1.資質(zhì)核驗:優(yōu)先選擇持有《司法鑒定許可證》、業(yè)務(wù)范圍含“法醫(yī)物證鑒定”,且實驗室通過CMA/CNAS認證的機構(gòu),可通過福建省司法廳官網(wǎng)查詢備案信息。
2.技術(shù)與設(shè)備:確認機構(gòu)合作實驗室配備主流基因測序設(shè)備(如ABI 3500xl),檢測位點不少于21個,確保結(jié)果準確性;詢問是否提供檢測流程追溯服務(wù)。
3.隱私保護:選擇實行“樣本編號+數(shù)據(jù)加密”的機構(gòu),明確鑒定完成后可申請銷毀原始樣本與個人信息,避免隱私泄露;查看是否有完善的隱私保護協(xié)議。
4.口碑與服務(wù):參考正規(guī)平臺客戶評價,優(yōu)先選擇服務(wù)流程清晰、工作人員專業(yè)的機構(gòu),避免選擇僅提供中介服務(wù)、無固定合作實驗室的場所。

四、東莞無創(chuàng)親子鑒定辦理流程
1.咨詢預(yù)約:通過正規(guī)渠道說明需求,告知孕周與健康狀況,獲取專屬預(yù)約編號及采樣指南,確認檢測周期(常規(guī)5-7個工作日)。
2.樣本采集:孕婦可到機構(gòu)采樣點采集10ml靜脈血(無需空腹),假定父親提供常規(guī)樣本(口腔拭子、帶毛囊毛發(fā)5-8根)或特殊樣本(煙頭、指甲等);也可自行采集后按指南密封郵寄(標注預(yù)約編號)。
3.樣本核驗與檢測:機構(gòu)收到樣本后24小時內(nèi)反饋驗收結(jié)果,合格樣本送入實驗室提取DNA,進行基因位點比對分析;不合格樣本可免費補發(fā)采樣工具。
4.報告領(lǐng)?。簷z測完成后,通過加密郵箱或匿名郵寄獲取報告,機構(gòu)提供免費結(jié)果解讀服務(wù),解答孕期相關(guān)疑問。
五、東莞無創(chuàng)親子鑒定中心手續(xù)材料
1.核心材料:無需提供身份證、戶口本等身份證明文件,支持匿名辦理,僅需提供被鑒定人樣本(孕婦靜脈血+假定父親樣本)。
2.輔助材料:孕婦需提供近期B超報告(確認孕周≥6周、胎兒存活狀態(tài)),便于機構(gòu)判斷檢測適配性;若假定父親提供特殊樣本,需提前告知樣本類型,確認是否符合檢測要求。
3.樣本包裝材料:自行采集樣本時,需使用機構(gòu)提供的無菌采樣管/密封袋,標注預(yù)約編號;郵寄時使用中性快遞面單,避免標注“無創(chuàng)親子鑒定樣本”等敏感信息,潮濕天氣可添加干燥劑防止DNA降解。
